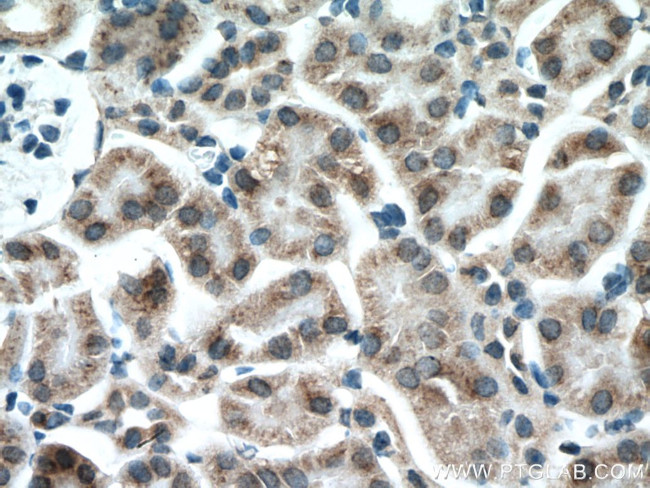
GALNT3 Antibody in Immunohistochemistry (Paraffin) (IHC (P))

Search
Proteintech
GALNT3 Polyclonal Antibody
{{$productOrderCtrl.translations['antibody.pdp.commerceCard.promotion.promotions']}}
{{$productOrderCtrl.translations['antibody.pdp.commerceCard.promotion.viewpromo']}}
{{$productOrderCtrl.translations['antibody.pdp.commerceCard.promotion.promocode']}}: {{promo.promoCode}} {{promo.promoTitle}} {{promo.promoDescription}}. {{$productOrderCtrl.translations['antibody.pdp.commerceCard.promotion.learnmore']}}
产品信息
16716-1-AP
种属反应
已发表种属
宿主/亚型
分类
类型
抗原
偶联物
形式
浓度
规格
纯化类型
保存液
内含物
保存条件
运输条件
产品详细信息
Immunogen sequence: MAHLKRLVK LHIKRHYHKK FWKLGAVIFF FIIVLVLMQR EVSVQYSKEE SRMERNMKNK NKMLDLMLEA VNNIKDAMPK MQIGAPVRQN IDAGERPCLQ GYYTAAELKP VLDRPPQDSN APGASGKAFK TTNLSVEEQK EKERGEAKHC FNAFASDRIS LHRDLGPDTR PPEYVEE (1-176 aa encoded by BC056246)
靶标信息
GALNT3 encodes UDP-GalNAc transferase 3, a member of the GalNAc-transferases family. This family transfers an N-acetyl galactosamine to the hydroxyl group of a serine or threonine residue in the first step of O-linked oligosaccharide biosynthesis. Individual GalNAc-transferases have distinct activities and initiation of O-glycosylation is regulated by a repertoire of GalNAc-transferases. The protein is highly homologous to other family members, however the enzymes have different substrate specificities.
仅用于科研。不用于诊断过程。未经明确授权不得转售。
生物信息学
蛋白别名: GalNAc transferase 3; GalNAc-T3; Polypeptide GalNAc transferase 3; polypeptide GalNAc-transferase T3; Polypeptide N-acetylgalactosaminyltransferase 3; pp-GaNTase 3; ppGaNTase-T3; Protein-UDP acetylgalactosaminyltransferase 3; UDP-GalNAc:polypeptide N-acetylgalactosaminyltransferase 3; UDP-N-acetyl-alpha-D-galactosamine:polypeptide N-acetylgalactosaminyltransferase 3 (GalNAc-T3); unnamed protein product
基因别名: GalNAc-T3; GALNT3; HFTC; HFTC1; HHS
UniProt ID: (Human) Q14435, (Mouse) P70419
Entrez Gene ID: (Human) 2591, (Rat) 366061, (Mouse) 14425